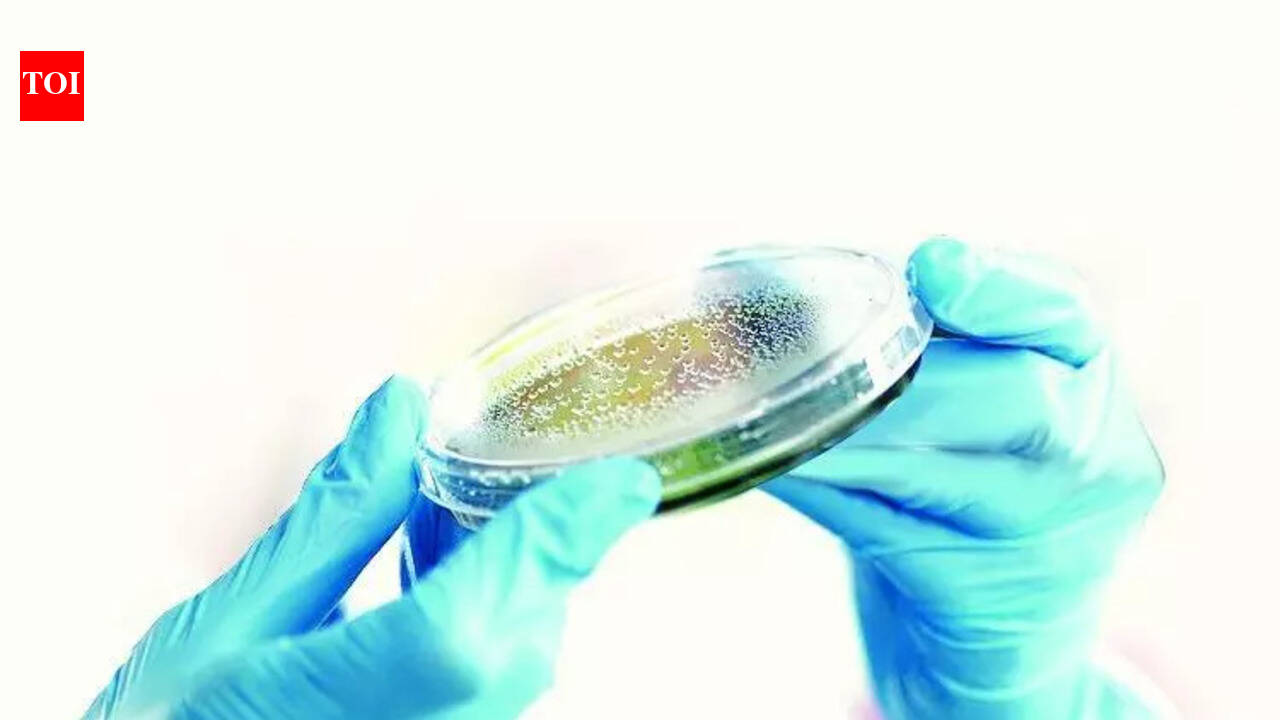
Bokaro admin steps up efforts to curb TB

ARTICLE AD BOX

COIMBATORE: The Podanur police in Coimbatore have issued a summons to a Chennai-based Instagram influencer in connection with the disappearance and subsequent rescue of four schoolgirls.According to police, four 12-year-old girls studying in Class VII at a private school in Podanur went missing on Tuesday. Their parents lodged a complaint at the Podanur police station.Coimbatore city police commissioner N Kannan formed two special teams to trace the missing girls. Police intensified the search, spotted the girls at Coimbatore Junction railway station and rescued them.Upon questioning, the girls said they were fans of a popular Instagram influencer named Monalisa, 22, and were travelling to Chennai to meet her. They claimed that they had sent a message to Monalisa informing her of their plan to visit her.Following the rescue, the girls underwent medical examinations and were handed over to their families.

 1 hour ago
5
1 hour ago
5

English (US) ·
English (US) ·